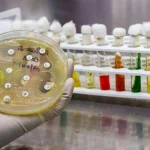
Medicina Personalizada de Precisión un eje clave frente a las resistencias antimicrobianas

La industria farmacéutica en España encara 2026 con una estrategia digital en plena evolución, marcada por un cambio de enfoque que prioriza el mensaje, la narrativa y la reputación frente a la mera presencia en plataformas. Así lo recoge el Informe anual ‘Posicionamiento digital de las farmacéuticas 2025’, elaborado por Cícero Comunicación, que, además de analizar el desempeño de cuarenta y siete compañías en redes sociales durante 2025, identifica las principales tendencias que definirán el entorno digital del sector en el próximo ejercicio.
El estudio se apoya en un análisis cuantitativo y cualitativo de la actividad de las compañías farmacéuticas en LinkedIn, Instagram, X y TikTok, durante el periodo comprendido entre el 1 de enero y el 31 de diciembre de 2025. A partir de estos datos, el informe no solo identifica las mejores prácticas del último año, sino que proyecta las claves estratégicas que, según el análisis, marcarán el posicionamiento digital del sector en 2026.
Uno de los principales mensajes del informe es que las redes sociales han dejado de concebirse como simples canales de difusión para convertirse en espacios de posicionamiento, conversación y construcción de reputación. Esta transformación, que se consolidó a lo largo de 2025, se profundizará en 2026, con una mayor exigencia en términos de coherencia narrativa y relevancia de los contenidos.

En palabras de Nuria Molina, directora de estrategia digital de Cícero Comunicación, “las redes sociales han dejado de ser un escaparate para convertirse en un espacio donde se construye reputación. En 2025 se confirma que no basta con estar: hay que aportar, conectar y sostener una narrativa que tenga sentido para cada audiencia y que esté optimizada para los modelos de IA”.
Esta visión resume buena parte de las tendencias que el informe anticipa para 2026, un año en el que el sector farmacéutico deberá adaptar sus estrategias digitales a un ecosistema cada vez más condicionado por la inteligencia artificial, la saturación de contenidos y la necesidad de generar conversación de valor.
De la plataforma al mensaje
Una de las tendencias más relevantes que el informe identifica de cara a 2026 es el desplazamiento definitivo del foco desde la plataforma hacia el mensaje. Según el análisis, las compañías farmacéuticas han avanzado en 2025 hacia estrategias más maduras, diferenciadas por canal, tipo de audiencia y objetivo de comunicación, una evolución que continuará en el próximo ejercicio.
El informe señala que esta madurez estratégica implica entender cada red social no solo como un canal con características técnicas específicas, sino como un entorno con dinámicas propias de conversación, consumo de información y generación de reputación. En este contexto, la simple adaptación de un mismo contenido a distintos formatos pierde eficacia frente a la construcción de relatos coherentes y sostenidos en el tiempo.
Para 2026, el estudio anticipa una consolidación de esta tendencia, con estrategias digitales que prioricen la aportación de valor y la conexión con las audiencias clave del sector, especialmente profesionales sanitarios, decisores y públicos especializados.
LinkedIn como eje reputacional
El informe destaca que LinkedIn se ha consolidado como el eje principal de la estrategia digital de más del 65 por ciento de las compañías farmacéuticas analizadas, una posición que previsiblemente mantendrá y reforzará en 2026. La plataforma se ha afianzado como el principal espacio para la comunicación corporativa, la difusión de avances científicos y la generación de vínculos con profesionales sanitarios.
Durante 2025, más del 65 por ciento de las compañías contaban con cuentas locales en LinkedIn, y el informe subraya que el rendimiento en esta red estuvo directamente relacionado con la consistencia del contenido y su alineación con una propuesta de valor clara. De cara a 2026, el estudio anticipa que esta exigencia será aún mayor, en un entorno cada vez más competitivo y saturado de información.
La tendencia apunta a un uso de LinkedIn más estratégico, orientado no solo a la visibilidad, sino al posicionamiento reputacional y a la generación de conversación en torno a temas relevantes para el sector sanitario y farmacéutico.
Narrativas visuales y coherencia editorial
Aunque LinkedIn ocupa una posición central, el informe también señala la importancia de mantener estrategias diferenciadas en otras plataformas. En el caso de Instagram, el análisis destaca su relevancia como canal de conexión con audiencias amplias, gracias a un lenguaje visual que permite combinar divulgación, concienciación y contenido corporativo.
Las estrategias que mejor funcionaron en 2025 fueron aquellas capaces de sostener una línea editorial clara, con formatos dinámicos y una propuesta coherente en el tiempo. Esta tendencia se proyecta hacia 2026, con una mayor apuesta por narrativas visuales que refuercen los mensajes clave de las compañías y contribuyan a la construcción de una identidad digital reconocible.
El informe subraya que esta coherencia editorial será un factor diferencial en un contexto en el que la atención de las audiencias es cada vez más limitada y fragmentada.
Conversación y especialización en X
En el caso de X, el estudio identifica su papel como canal clave para la comunicación en tiempo real y la participación en debates especializados del sector. A pesar del contexto de cambios que vive la plataforma, el informe señala que mantiene su relevancia para amplificar mensajes, generar visibilidad y reforzar el posicionamiento en temas de interés profesional.
De cara a 2026, la tendencia apunta a un uso más selectivo y especializado de X, centrado en la participación en conversaciones relevantes y en la divulgación de contenidos alineados con la agenda del sector sanitario y farmacéutico.
TikTok y el potencial de crecimiento
El informe dedica también un apartado al análisis de TikTok, una plataforma que, pese a contar todavía con una presencia limitada en el sector farmacéutico, muestra un alto potencial de crecimiento. Durante 2025, solo dos compañías, Cinfa y Roche, contaban con presencia activa en este canal.
Según el análisis, la combinación de contenido educativo y entretenimiento, junto con inversión publicitaria aplicada con criterio, puede ser determinante para amplificar resultados. De cara a 2026, el informe anticipa que más compañías podrían explorar este canal, especialmente para aumentar alcance y engagement con nuevos públicos.
La irrupción de los modelos de IA
Una de las tendencias más destacadas que el informe identifica para 2026 es la generación de contenidos optimizados para ser fuente en respuestas de modelos de inteligencia artificial. Según el estudio, este enfoque representa un cambio significativo en la forma de concebir la estrategia digital, ya que obliga a pensar los contenidos no solo para audiencias humanas, sino también para sistemas automatizados de búsqueda y respuesta.
El informe señala que esta tendencia ya comenzó a vislumbrarse en 2025, pero que cobrará mayor relevancia en 2026, a medida que los modelos de IA ganen peso como intermediarios en el acceso a la información. En este contexto, la claridad, la fiabilidad y la relevancia de los contenidos se convierten en factores clave para el posicionamiento digital de las compañías farmacéuticas.
Datos, análisis y escucha activa
El estudio de Cícero Comunicación se apoya en herramientas como Metricool para la recopilación de datos sobre publicaciones, interacciones, alcance y crecimiento, así como en Brandwatch para el social listening y la identificación de temas de conversación. Este enfoque metodológico refuerza otra de las tendencias que el informe proyecta hacia 2026: la importancia del análisis de datos y la escucha activa para orientar la estrategia digital.
Según el informe, las compañías que mejor desempeño registraron en 2025 fueron aquellas capaces de interpretar los datos y adaptar sus contenidos a las expectativas y necesidades de sus audiencias. De cara a 2026, esta capacidad analítica será aún más relevante en un entorno digital cada vez más complejo.
Un entorno más exigente
En conjunto, el informe concluye que el entorno digital farmacéutico de 2026 será más exigente en términos de coherencia, relevancia y capacidad de generar conversación. Las redes sociales se consolidan como espacios estratégicos para el posicionamiento y la reputación, y la irrupción de la inteligencia artificial añade una nueva capa de complejidad a la planificación de contenidos.
Las tendencias identificadas por Cícero Comunicación apuntan a un escenario en el que no bastará con mantener presencia en redes sociales, sino que será necesario desarrollar estrategias sólidas, basadas en el valor del contenido, la comprensión de las audiencias y la adaptación a los nuevos intermediarios digitales. En este contexto, el posicionamiento digital se perfila como un elemento cada vez más estratégico para las compañías farmacéuticas en España.

César Hernández, director general de Cartera y Farmacia del Ministerio de Sanidad:
Kilian Sánchez, secretario de Sanidad del PSOE y portavoz de la Comisión de Sanidad del Senado.:
Rocío Hernández, consejera de Salud de Andalucía:
Nicolás González Casares, eurodiputado de Socialistas & Demócratas (S&D - PSOE):
Juan José Pedreño, consejero de Salud de Murcia: